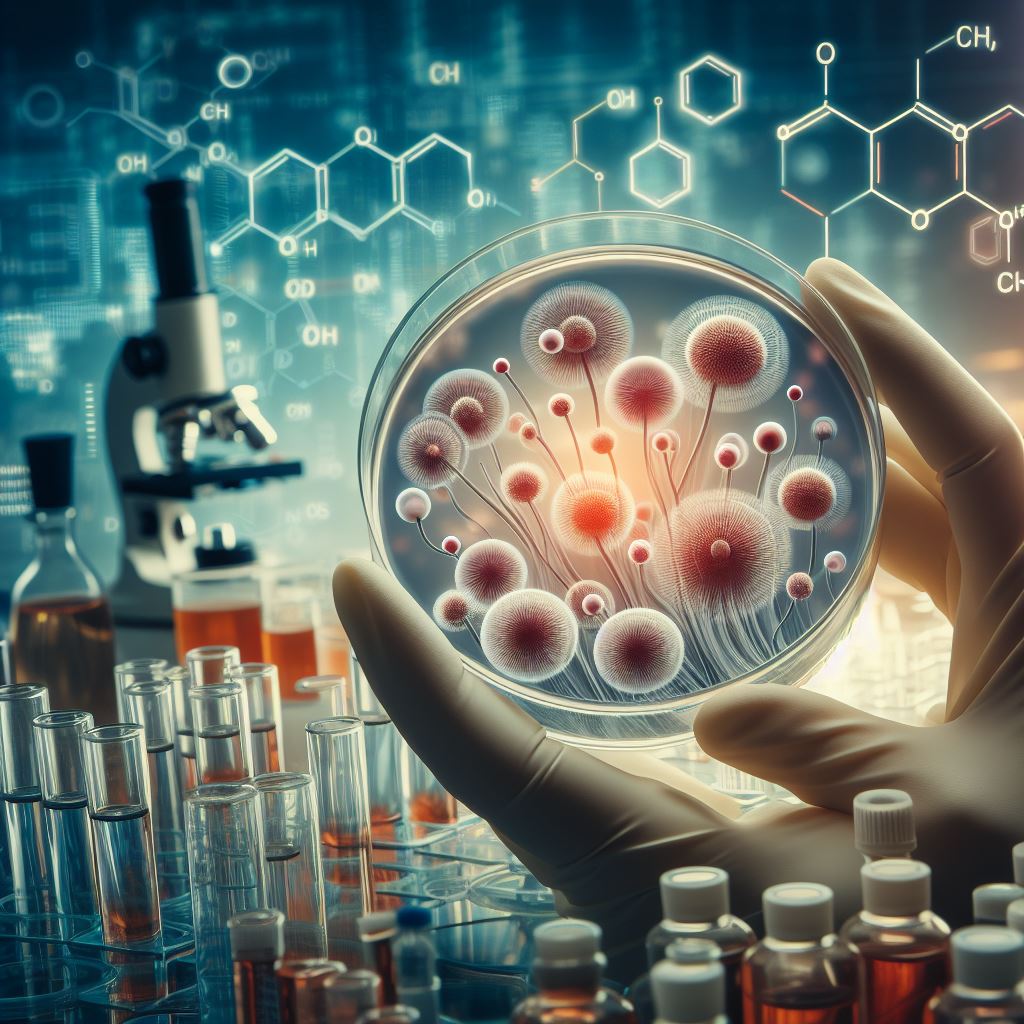

Materiały do ćwiczeń z przedmiotu Ochrona Roślin, prowadzonego przez Zakład Fitopatologii i Mykologii na kierunkach Ogrodnictwo i Rolnictwo.
Materiały do ćwiczeń z przedmiotu Ochrona Roślin, prowadzonego przez Zakład Fitopatologii i Mykologii na kierunkach Ogrodnictwo i Rolnictwo.